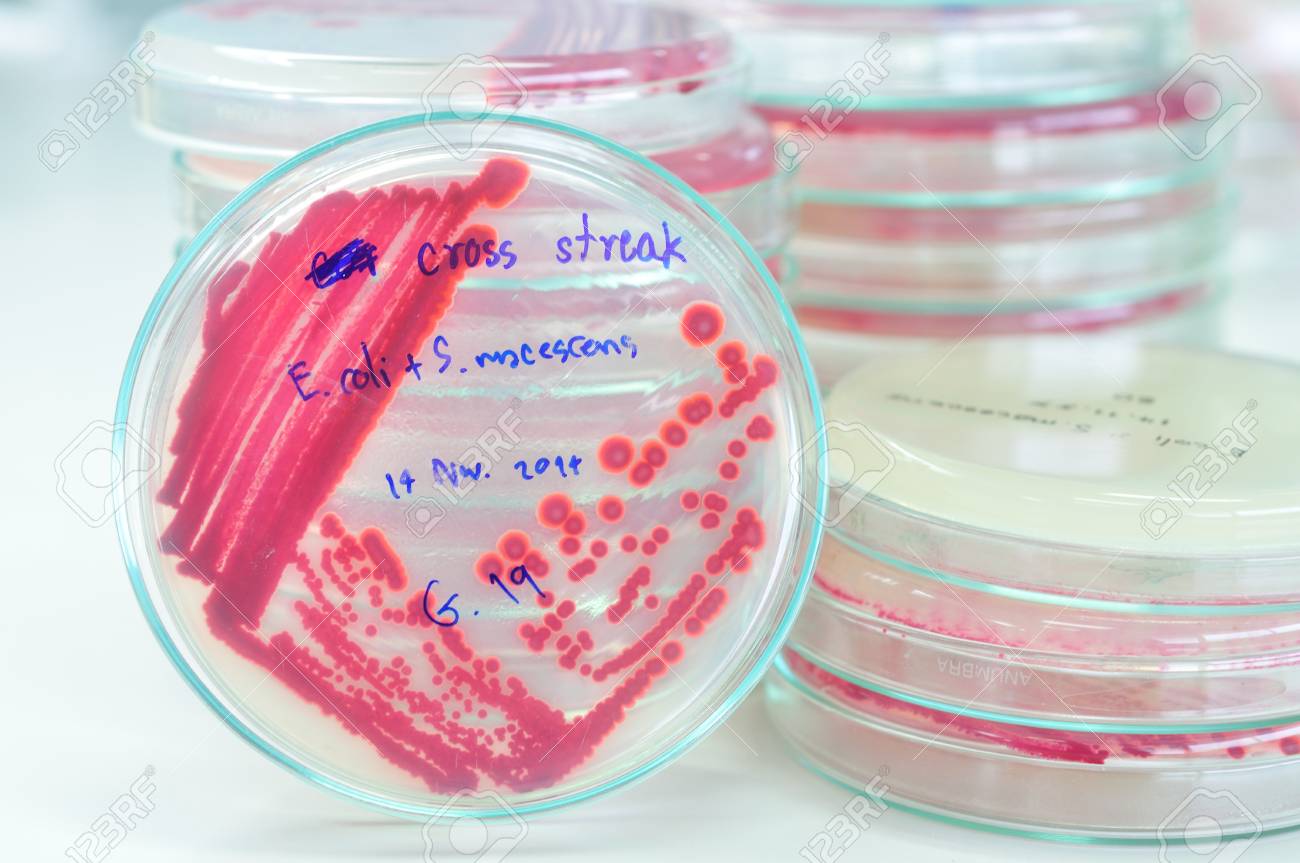
etiam-dictum-ipsum-a-felis

Download
Close
Автор:
id:
Ключевые слова:
agar, antibiotic, bacteria, bacterial, biology, biotechnology, blue, chemical, colony, culture, dish, drug, education, experiment, experimental, fungi, grow, growth, healthcare, investigation, lab, laboratory, macro, medical, medicine, microbiology, microorganisms, molecular, organism, penicillin, penicillum, petri, plate, research, science, strain, study,





